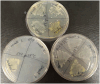

Interaction of bacteriophage P1 with an epiphytic Pantoea agglomerans strain-the role of the interplay between various mobilome elements
- PMID: 38591037
- PMCID: PMC10999674
- DOI: 10.3389/fmicb.2024.1356206
Interaction of bacteriophage P1 with an epiphytic Pantoea agglomerans strain-the role of the interplay between various mobilome elements
Abstract
P1 is a model, temperate bacteriophage of the 94 kb genome. It can lysogenize representatives of the Enterobacterales order. In lysogens, it is maintained as a plasmid. We tested P1 interactions with the biocontrol P. agglomerans L15 strain to explore the utility of P1 in P. agglomerans genome engineering. A P1 derivative carrying the Tn9 (cmR) transposon could transfer a plasmid from Escherichia coli to the L15 cells. The L15 cells infected with this derivative formed chloramphenicol-resistant colonies. They could grow in a liquid medium with chloramphenicol after adaptation and did not contain prophage P1 but the chromosomally inserted cmR marker of P1 Tn9 (cat). The insertions were accompanied by various rearrangements upstream of the Tn9 cat gene promoter and the loss of IS1 (IS1L) from the corresponding region. Sequence analysis of the L15 strain genome revealed a chromosome and three plasmids of 0.58, 0.18, and 0.07 Mb. The largest and the smallest plasmid appeared to encode partition and replication incompatibility determinants similar to those of prophage P1, respectively. In the L15 derivatives cured of the largest plasmid, P1 with Tn9 could not replace the smallest plasmid even if selected. However, it could replace the smallest and the largest plasmid of L15 if its Tn9 IS1L sequence driving the Tn9 mobility was inactivated or if it was enriched with an immobile kanamycin resistance marker. Moreover, it could develop lytically in the L15 derivatives cured of both these plasmids. Clearly, under conditions of selection for P1, the mobility of the P1 selective marker determines whether or not the incoming P1 can outcompete the incompatible L15 resident plasmids. Our results demonstrate that P. agglomerans can serve as a host for bacteriophage P1 and can be engineered with the help of this phage. They also provide an example of how antibiotics can modify the outcome of horizontal gene transfer in natural environments. Numerous plasmids of Pantoea strains appear to contain determinants of replication or partition incompatibility with P1. Therefore, P1 with an immobile selective marker may be a tool of choice in curing these strains from the respective plasmids to facilitate their functional analysis.
Keywords: Pantoea agglomerans complete genome sequence; Tn9 and mobile antibiotic resistance marker; bacteriophage P1; lysogeny; plasmid curing; plasmid-prophage; replication and partition incompatibility; transduction.
Copyright © 2024 Giermasińska-Buczek, Gawor, Stefańczyk, Gągała, Żuchniewicz, Rekosz-Burlaga, Gromadka and Łobocka.
Conflict of interest statement
The authors declare that the research was conducted in the absence of any commercial or financial relationships that could be construed as a potential conflict of interest.
Figures

Similar articles
-
[Introduction of transpozon Tn9 to endogenic plasmids of Erwinia carotovora during lysogenization of cells by coliphage P1].Mikrobiol Z. 2006 Jul-Aug;68(4):34-9. Mikrobiol Z. 2006. PMID: 17100326 Russian.
-
Transposition of IS1-lambdaBIO-IS1 from a bacteriophage lambda derivative carrying the IS1-cat-IS1 transposon (Tn9).Mol Gen Genet. 1980 Apr;178(1):111-20. doi: 10.1007/BF00267219. Mol Gen Genet. 1980. PMID: 6247615
-
New developments on the generation of mutations in Escherichia coli lysogens.Acta Microbiol Hung. 1989;36(4):377-413. Acta Microbiol Hung. 1989. PMID: 2561868
-
Some properties of the chloramphenicol resistance transposon Tn9.Mol Gen Genet. 1979 Oct 3;176(2):221-31. doi: 10.1007/BF00273216. Mol Gen Genet. 1979. PMID: 393954
-
On the origin of the chloramphenicol resistance transposon Tn9.J Gen Microbiol. 1983 Apr;129(4):1217-25. doi: 10.1099/00221287-129-4-1217. J Gen Microbiol. 1983. PMID: 6310027
References
-
- Adams M. H. (1959). Bacteriophages. New York, NY: Interscience Publishers Inc.
LinkOut - more resources
Full Text Sources
Miscellaneous